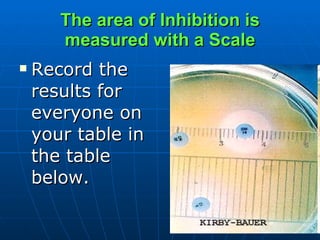
The area of Inhibition is measured with a Scale Record the results for everyone on your table in the table below.

Antibiotic sensitivity testing determines how effective antibiotic therapy is against bacterial infections. It involves identifying pathogens from patient samples, testing their sensitivity to antibiotics, and determining the appropriate dosage. Kirby-Bauer disk diffusion is a common method that uses antibiotic-impregnated disks placed on inoculated agar plates, and the zone of growth inhibition is measured to determine sensitivity. Regular testing is needed since bacteria can develop resistance over time.